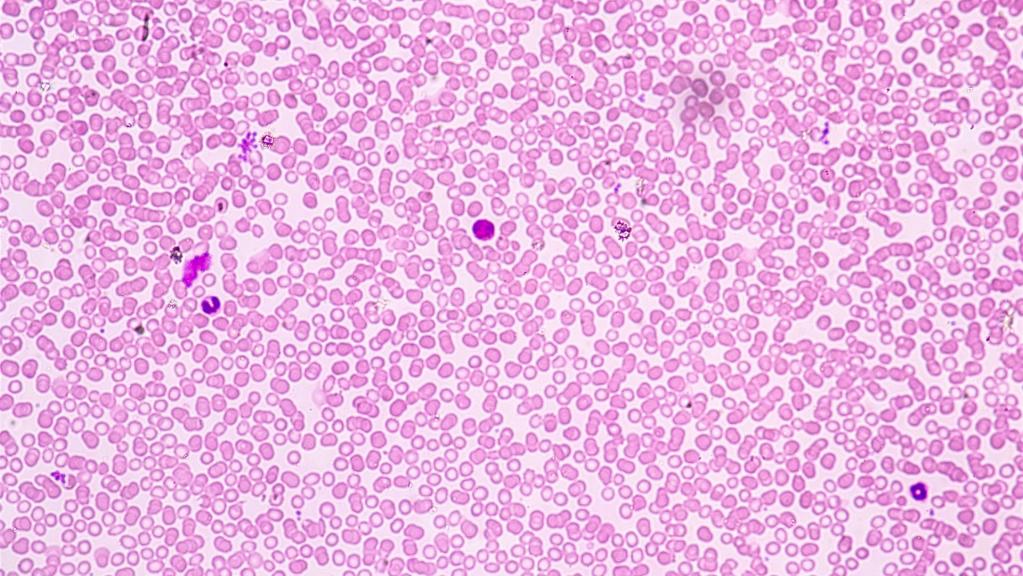

-
Zielgruppe
Osteopathen
Abgeschlossenes Grundstudium
(für Studierende am AVT-College)
-
Seminargebühr:
300,- Euro / 285,- Euro für DVOM-Mitglieder
-
CME-Credits
Für dieses Modul werden 2 x 20 CME-Credits vergeben
-
Zuordnung
Vertiefungsstudium / Klinische Chemie / Continuing Medical Education (CME)
Modul |
Termin des Seminars |
Kurs-Nr.: |
Seminarort: |
---|---|---|---|
Teil 1 |
25.-26.09.2026 |
KC 1-26-1 | |
Teil 2 |
12.-13.09.2025 |
KC 2-25-1 | |
Teil 2 |
20.-21.12.2026 |
KC 2-26-1 |

Lehrinhalte Teil 1
Probengewinnung (Kapillarblut / Venenblut)
Präanalytik
Hämatopoese
Einfache Bestimmung von Ery, HB und HCT
Bestimmung der Leukozytenzahl
Färbung eines Blutausstrichs nach Pappenheim
Blutsenkungsgeschwindigkeit
Lehrinhalte Teil 2
Differentialblutbild
CRP-Bestimmung
Laktat-Bestimmung
Thrombozyten-Bestimmung
Untersuchung des Harns
Färbung und Beurteilung des Harnsediments
Urikult-Test
Labormedizin / Klinische Chemie Teil 1
Artikelnummer: | KC 1-26-1 |
25.-26.09.2026
300,00 €
Zzgl. Versand. Als Kleinunternehmer wird keine USt. berechnet.
Labormedizin / Klinische Chemie Teil 1 - DVOM Mitglied
Artikelnummer: | KC 1-26-1 |
25.-26.09.2026
285,00 €
Zzgl. Versand. Als Kleinunternehmer wird keine USt. berechnet.
Labormedizin / Klinische Chemie Teil 2
Artikelnummer: | KC 2-25-1 |
12.-13.09.2025
300,00 €
Zzgl. Versand. Als Kleinunternehmer wird keine USt. berechnet.
Labormedizin / Klinische Chemie Teil 2 - DVOM Mitglied
Artikelnummer: | KC 2-25-1 |
12.-13.09.2025
285,00 €
Zzgl. Versand. Als Kleinunternehmer wird keine USt. berechnet.
Labormedizin / Klinische Chemie Teil 2
Artikelnummer: | KC 2-26-1 |
20.-21.12.2026
300,00 €
Zzgl. Versand. Als Kleinunternehmer wird keine USt. berechnet.
Labormedizin / Klinische Chemie Teil 2 - DVOM Mitglied
Artikelnummer: | KC 2-26-1 |
20.-21.12.2026
285,00 €
Zzgl. Versand. Als Kleinunternehmer wird keine USt. berechnet.